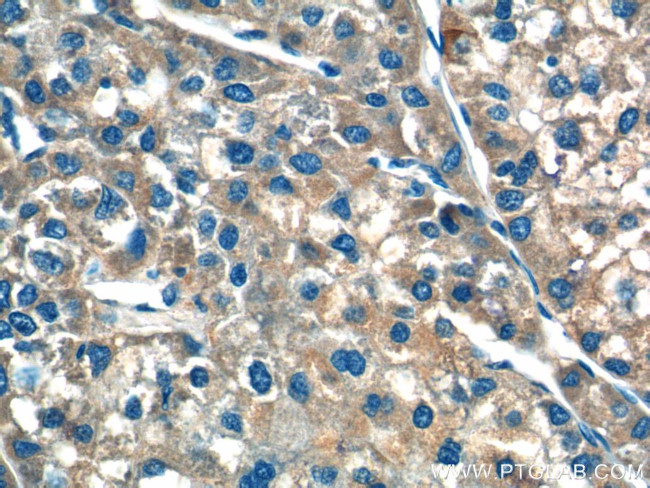
F9 Antibody in Immunohistochemistry (Paraffin) (IHC (P))

Search
Proteintech
F9 Polyclonal Antibody
{{$productOrderCtrl.translations['antibody.pdp.commerceCard.promotion.promotions']}}
{{$productOrderCtrl.translations['antibody.pdp.commerceCard.promotion.viewpromo']}}
{{$productOrderCtrl.translations['antibody.pdp.commerceCard.promotion.promocode']}}: {{promo.promoCode}} {{promo.promoTitle}} {{promo.promoDescription}}. {{$productOrderCtrl.translations['antibody.pdp.commerceCard.promotion.learnmore']}}
产品信息
21481-1-AP
种属反应
已发表种属
宿主/亚型
分类
类型
抗原
偶联物
形式
浓度
规格
纯化类型
保存液
内含物
保存条件
运输条件
产品详细信息
Immunogen sequence: ELDVTCNIK NGRCEQFCKN SADNKVVCSC TEGYRLAENQ KSCEPAVPFP CGRVSVSQTS KLTRAETVFP DVDYVNSTEA ETILDNITQS TQSFNDFTRV VGGEDAKPGQ FPWQVVLNGK VDAFCGGSIV NEKWIVTAAH CVETGVKITV VAGEHNIEET EHTEQKRNVI RIIPHHNYNA AINKYNHDIA LLELDEPLVL NSYVTPICIA DKEYTNIFLK FGSGYVSGWG RVFHKGRSAL VLQYLRVPLV DRATCLRSTK FTIYNNMF (129-395 aa encoded by BC109215)
靶标信息
Coagulation factor IX is a single chain polypeptide with a molecular mass of 57 kDa. Normal concentrations of factor IX in human plasma is approximately 3 µg/mL. Factor IX deficiency and lack of coagulation activity is seen in patients suffering from the innate X-chromosome linked disorder, haemophilia B.
仅用于科研。不用于诊断过程。未经明确授权不得转售。
生物信息学
蛋白别名: Christmas factor; coagulation factor; Coagulation factor IX; coagulation factor IX precursor; EC 3.4.21.22; factor 9; factor IX (Christmas factor) precursor; factor IX F9; Factor9; FIX F9; plasma thromboplastic component; Plasma thromboplastin component; PTC; RP6-88D7.1; serine protease; unnamed protein product
基因别名: F9; F9 p22; FIX; HEMB; P19; PTC; THPH8
UniProt ID: (Human) P00740
Entrez Gene ID: (Human) 2158